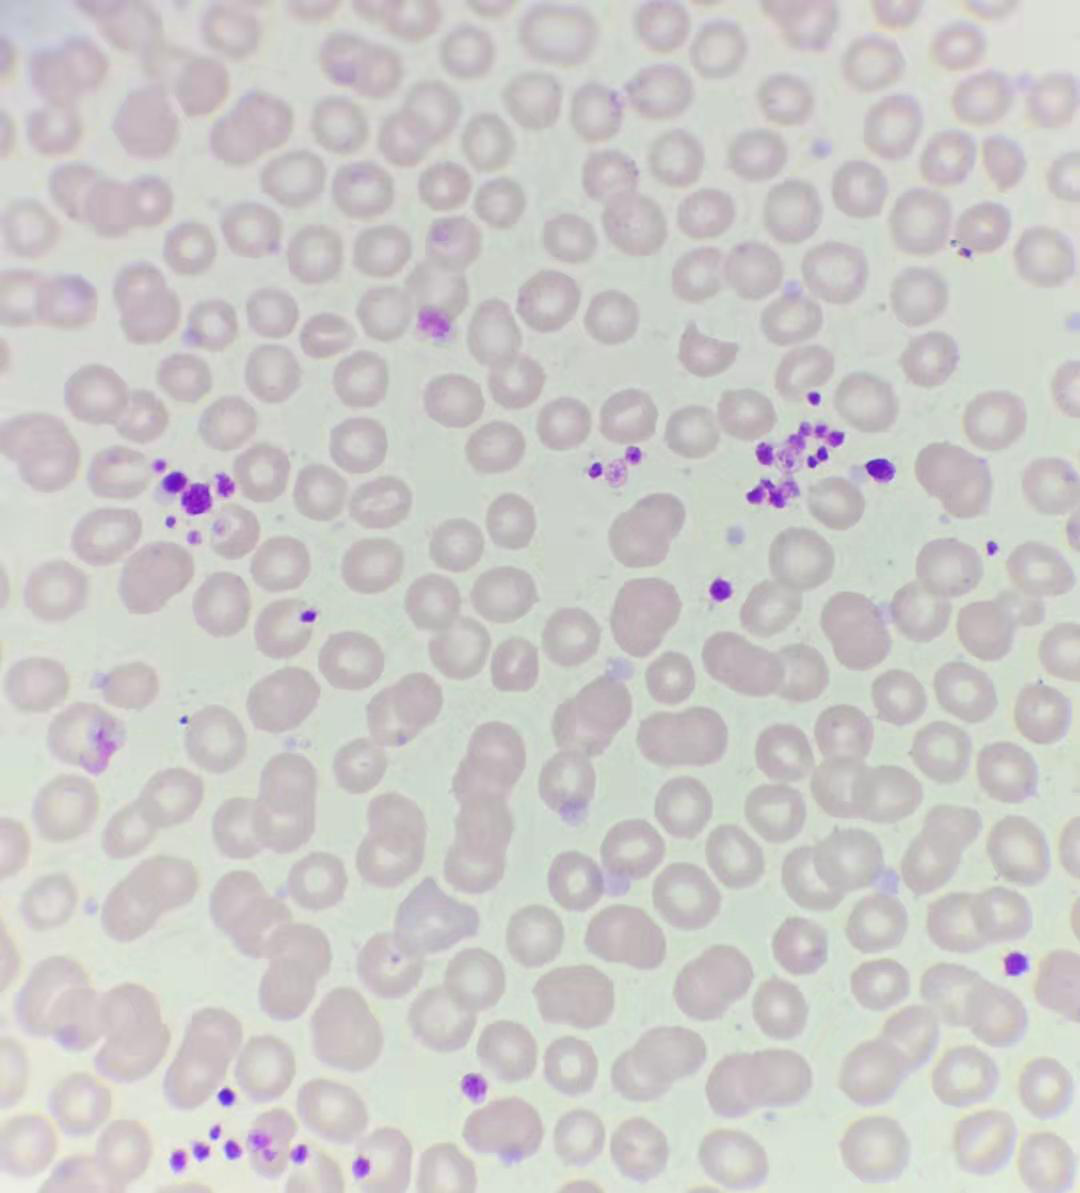

8月26日上午,检验科临检室为一门诊患者行血常规检测时,发现该患者血小板只有16×10的9次方/L,已经达到危急值,于是对其推片显微镜下复检时,镜下可见血小板聚集,考虑患者有可能为EDTA依赖性假性血小板减少,于是重新更换为肝素、枸橼酸钠抗凝管都没有被纠正,镜下均发现血小板聚集,最后当场采用无抗凝剂管当场抽血上机及结合血涂片血小板结果,该患者血小板纠正为177×10的9次方/L,属于正常范围。
血涂片瑞氏染色x1000 血小板聚集
由于EDTA抗凝剂不影响血细胞的形态,所以,被国际血液标准委员会(ICSH)推荐,作为血细胞计数首选的抗凝剂。EDTA依赖性假性血小板减少症文献报道发生率0.07%~0.20%,与年龄、性别无明显相关性。其机制可能与某些存在于血小板表面的隐匿性抗原有关。EDTA可活化血小板,诱发其表面某些隐匿性抗原表位构象发生改变,与血浆中的自身抗体结合后,激活了细胞膜中的某些能活化使血小板与纤维蛋白原受体的活性物质,促使血小板与纤维蛋白原聚集,引发血小板互相聚集。目前国内外报道主要集中在EDTA依赖性假性血小板减少,EDTA和肝素、枸橼酸钠同时依赖的假性血小板减少比较少见,其机制尚不明确。
需要与哪些疾病鉴别?
(1)免疫性血小板减少:血常规可提示血小板明显减少,伴有典型出血倾向,如皮肤黏膜的出血点或鼻衄、牙龈出血等。
(2)血液系统疾病:如急性白血病、再生障碍性贫血等,有时早期可仅仅表现为血小板减少,需要通过血细胞分类等进一步鉴别。
(3)肿瘤:淋巴瘤、骨髓转移癌等。
(4)自身免疫性疾病:最常见为系统性红斑狼疮,干燥综合征,APS等。
(5)感染及药物因素:脓毒血症、肝炎病毒、EB病毒感染等及某些抗生素和化疗药物均可引起血小板减少。
(6)其它:TTP、溶血尿毒综合征(HUS)、DIC等。
抗凝剂依赖性血小板假性减少需要治疗吗?
“抗凝剂依赖性血小板假性减少”是由抗凝剂引起的发生在体外的血小板聚集现象。既然是假性减少,说明并不是生理性或者病理性减少,是不需要治疗的。但是,准确判断很重要,以免误诊或延误其他疾病的治疗。
对于此类患者再次做血常规时有什么建议?
对于抗凝剂依赖血小板假性减少的患者,日后就诊时,可以提前与检验科沟通,我们可以根据患者自身情况选择合适检测方法,避免重复抽血耽误就诊时间。